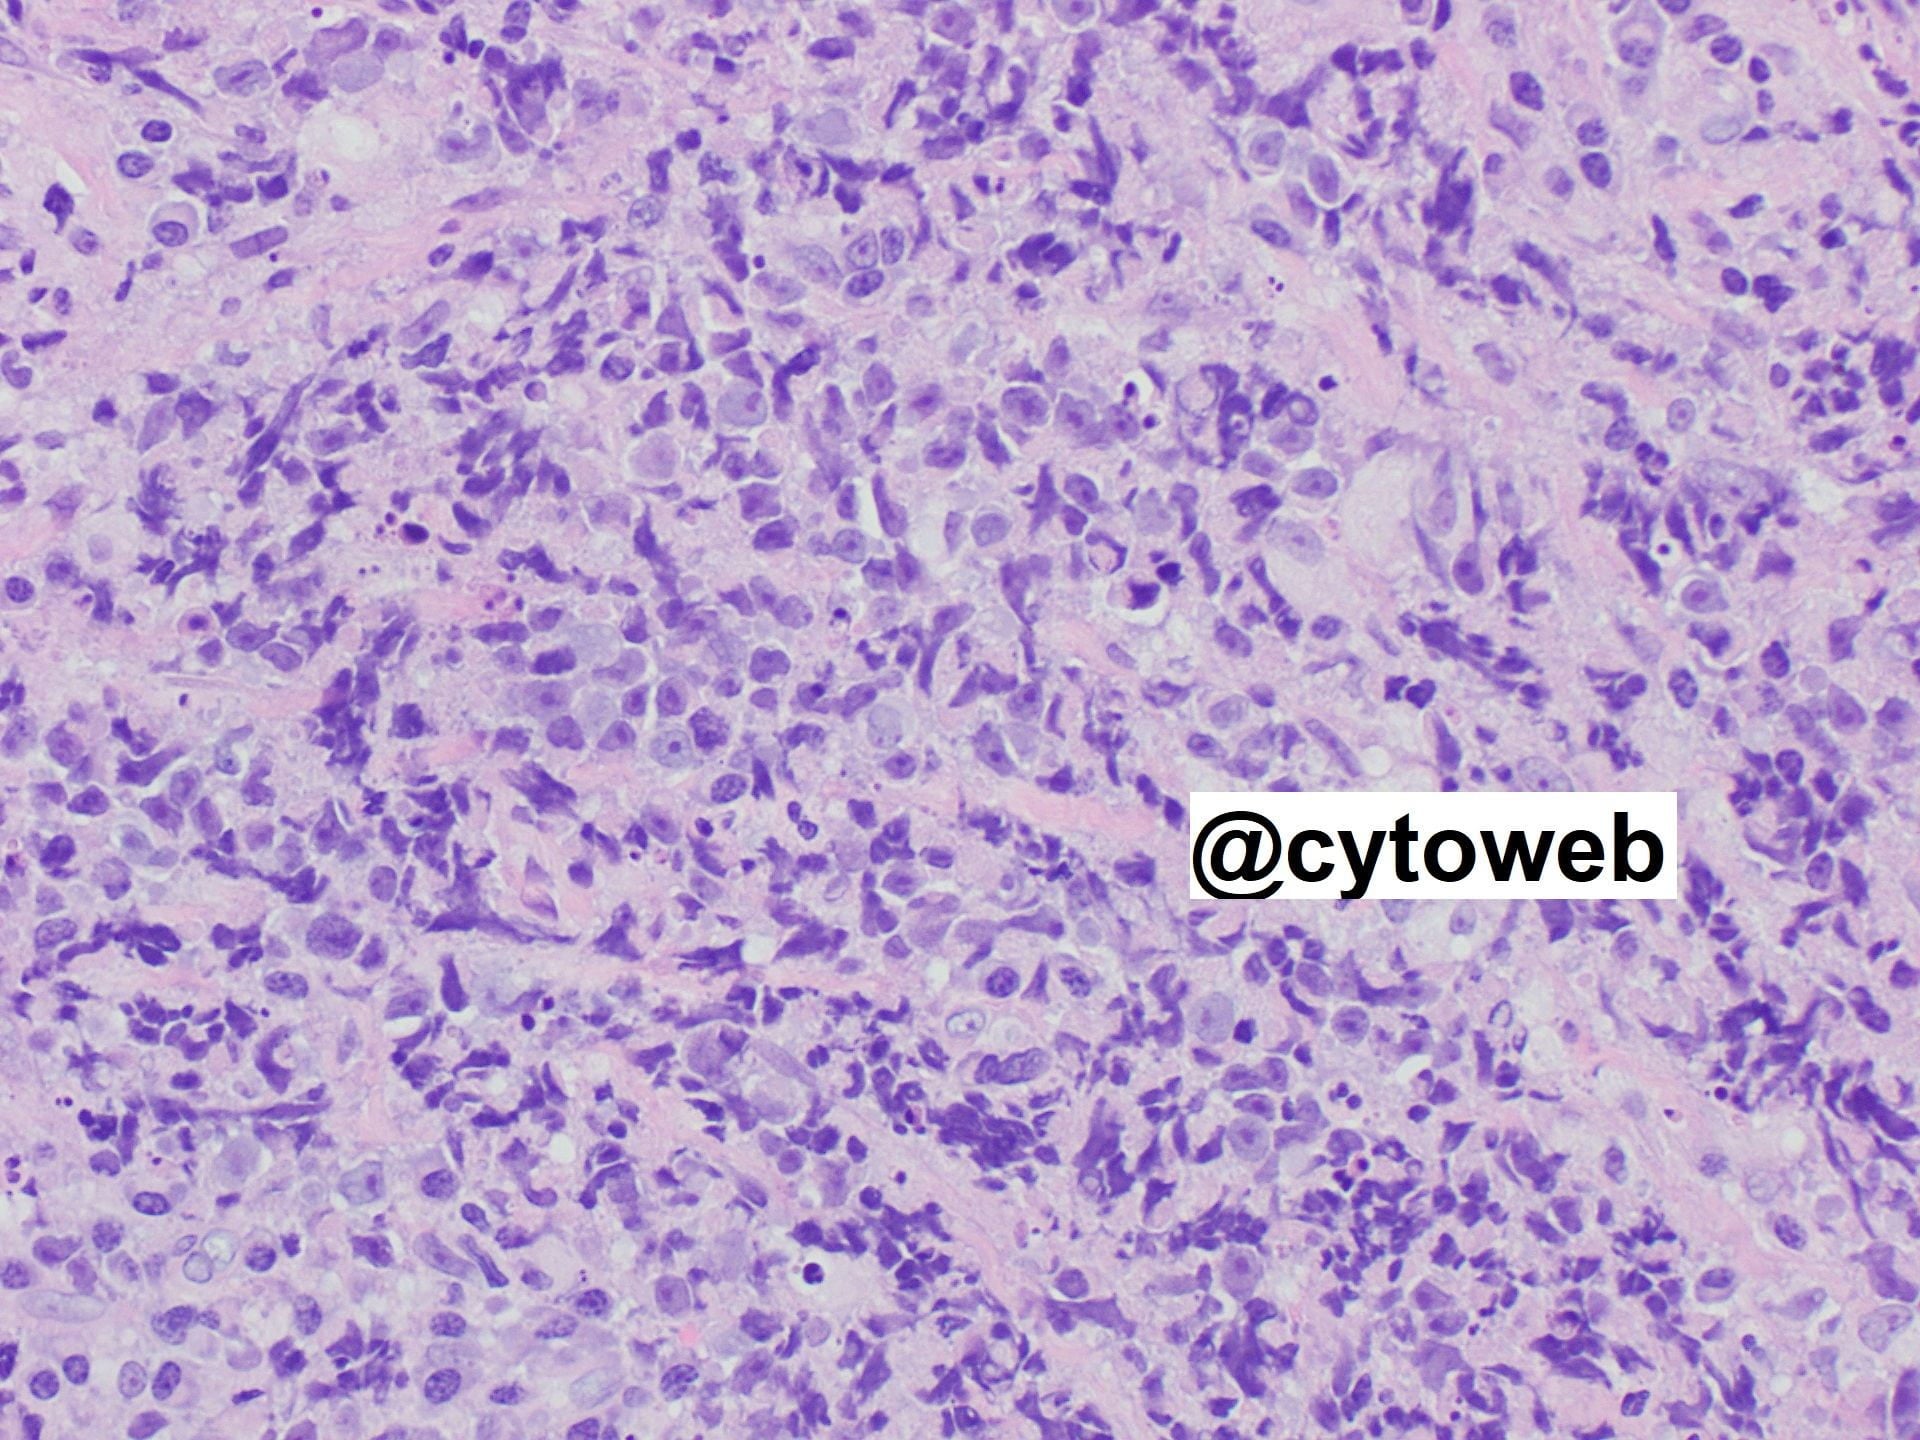
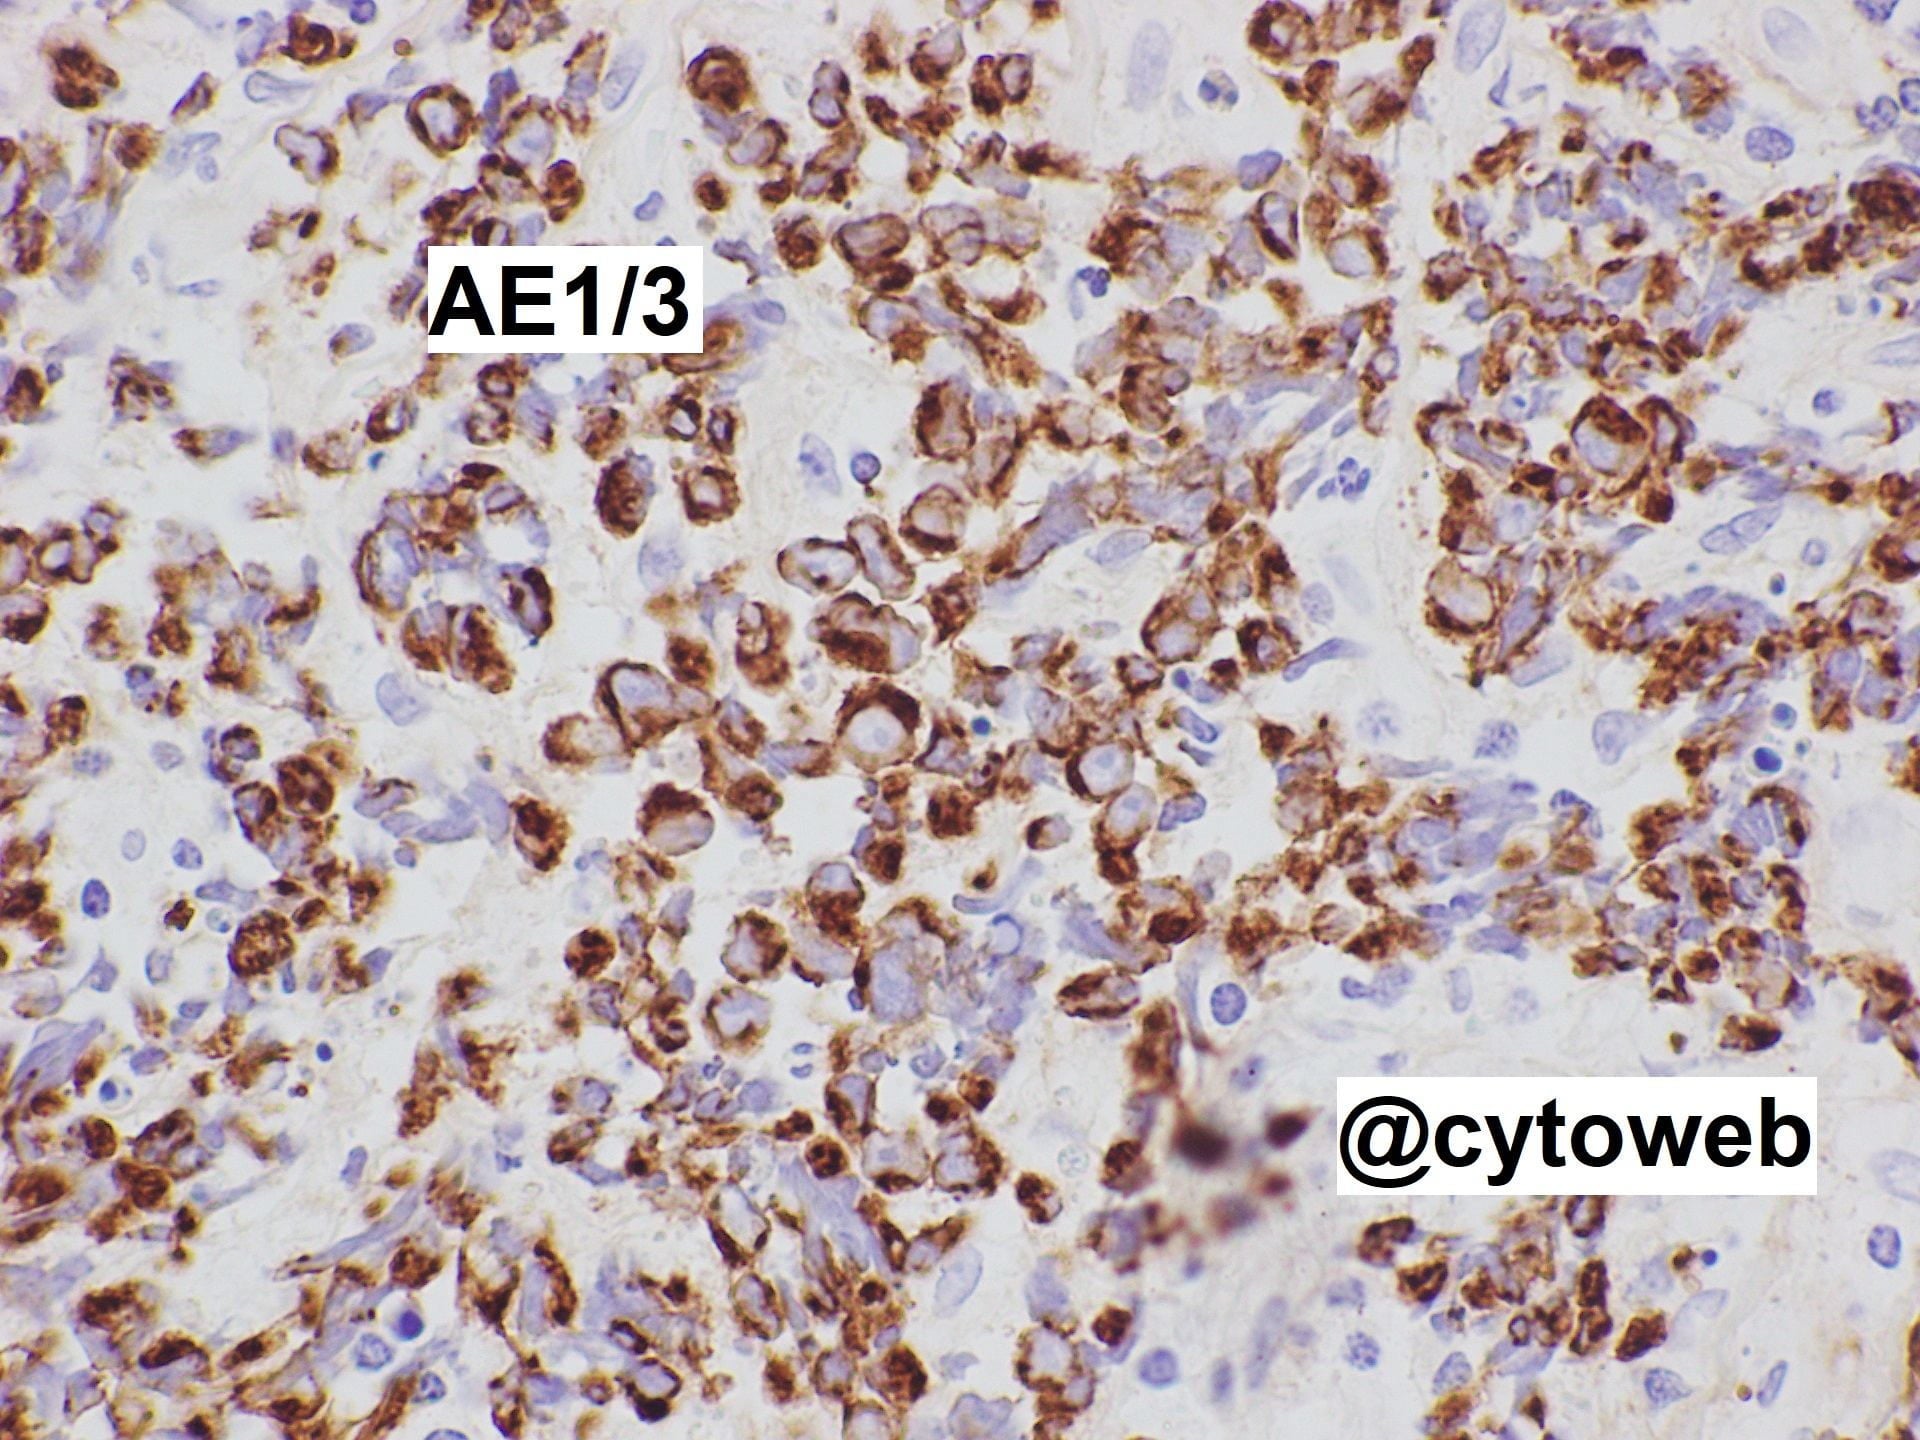

Lymph node case 1
A case of cervical lymphadenopathy
Clinical history: 49yo M with no past medical history, presents with left then right neck lumps, a blocked left ear and intermittent blood-tinged saliva. Clinical examination reveals bilateral enlarged cervical lymph nodes. The largest one is a left level II cervical lymph node measuring 3-4 cm in size.
Ultrasound-guided fine needle aspiration of the left level II cervical lymph node was performed.
Case writer: Dr Nicholas Tan